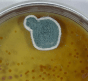
пенициллин

8(800) 350-08-07 Заказать звонок
Сообщение отправлено
Ваше сообщение успешно отправлено. В ближайшее время с Вами свяжется наш специалист
Закрыть окно
10 самых важных открытий и изобретений в нашей истории
Всякий раз в истории нашего мира человечество достигало той точки, где, казалось бы, зашло в тупик и препятствие не преодолеть, находились те, кто искал решения, продвигая нашу цивилизацию вперед, обогащая нашу культуру и внедряя в повседневную жизнь новые изобретения.Вот несколько самых важных изобретений в мировой истории, без которых трудно представить нашу жизнь сегодня.
 1. Одним из важнейших изобретений человечества считается колесо, возникшее примерно за три с половиной тысячи лет до нашей эры. На протяжении всей истории оно использовалось не только для всех видов транспортных средств, но и для оборудования и производственных машин. Было бы трудно сосчитать любые конструкции, в которых этот элемент необходим.
1. Одним из важнейших изобретений человечества считается колесо, возникшее примерно за три с половиной тысячи лет до нашей эры. На протяжении всей истории оно использовалось не только для всех видов транспортных средств, но и для оборудования и производственных машин. Было бы трудно сосчитать любые конструкции, в которых этот элемент необходим.2. Примерно в 100 году нашей эры в Китае была создана бумага. Это изобретение до сих пор не потеряло своей ценности и не было заменено более новой моделью.
3. Изобретение часов стало прорывом для человечества. До того, как в барокко появились первые карманные часы, ставшие впоследствии символом эпохи, люди ориентировались во времени с помощью солнечных и песочных часов.
 4. В 1879 году Томас Эдисон изобрел лампочку, источник света, используемый сегодня в каждом доме, который постепенно вытеснил газовое освещение и керосиновые лампы.
4. В 1879 году Томас Эдисон изобрел лампочку, источник света, используемый сегодня в каждом доме, который постепенно вытеснил газовое освещение и керосиновые лампы.5. В 1894 году Гульельмо Маркони изобрел радио. Это позволило капитанам воздушных кораблей, которые кружили над землей, преодолевая тысячи миль через океаны, оставаться на связи друг с другом.
6. В 1895 году Огюст и Луи Люмьер, братья из Франции, разработали кинематограф, что привело к большому увлечению кино во всем мире. Их первый показ фильмов в парижском кафе произвел фурор.
7. В 1903 году Орвилл и Уилбур Райт совершили первый полет на самолете. Он был не длинным, самолет пролетел в длину чуть больше, чем его собственный размер, и все же с этого момента мир готовился к большим изменениям в этой отрасли.
8. В 1928 году Александр Флеминг дал миру пенициллин, который был первым в истории антибиотиком.
8. В 1928 году Александр Флеминг дал миру пенициллин, который был первым в истории антибиотиком.9. В 1969 году Нил Армстронг и Эдвин Олдрин были первыми людьми, которые высадились на Луну. Это было эпохальное событие и преодоление границ, которые были непроходимы для людей в течение тысяч лет.
10. В 1967 году Кристиан Барнард сделал первую пересадку сердца, дав надежду миллионам людей, для которых порок сердца был до этого момента приговором.
Приобрести smart приставки можно на нашем сайте в этом разделе.
Подпишитесь на канал «ЭЛЕКТРОНИКА GA» в Telegram: перейдите по инвайт-ссылке или в поисковой строке мессенджера введите @antenna123ru, затем выберите канал «ЭЛЕКТРОНИКА GA» и нажмите кнопку +Join внизу экрана.
Также читайте наши Блоги, Новости, узнавайте про Акции во «ВКонтакте», «Одноклассниках».
Другие записи
Беспроводные камеры видеонаблюдения - особенности
Видеонаблюдение в настоящее время присутствует практически везде. Увидеть его можно на частных территориях, в подъездах и лифтах, на улицах, в магазинах и в организациях. Наиболее современными его вариантами являются системы, оснащенные беспроводными камерами. Они обладают некоторыми особенностями, повышающими функциональность видеонаблюдения.
Подробнее
Как можно скачать видео с ютуба?
Многие сталкивались с проблемой: как можно скачать видео с ютуба (YouTube). Вам понравился ролик, выложенный на YouTube, захотелось сохранить его на компьютер, а как это сделать? Хочу показать как это можно сделать, сразу скажу, что способов достаточно много, но если вы будете знать хотя бы парочку, думаю вам этого хватит.
Подробнее
Как сохранить консольные игры Wii?
С возникновением новых Wii консолей стала появляться проблема, где можно скачать игры для неё. Поиск программ в локальной сети особого результата не дал, то, что было обнаружено, было весьма малой толикой информации. Однако недавно в интернете появилось ПО, которое работает просто фантастически. Несколько месяцев назад копирование таких игр была просто невыносимо сложной задачей. И в данный момент многое изменилось, можно позабыть о головных болях, связанных с сохранением консольных игр, теперь у вас есть возможность просто скопировать игры в три простых этапа.
Подробнее
- Комментарии
Добавить комментарий
Загрузка комментариев...

 Каталог товаров
Каталог товаров 
















































